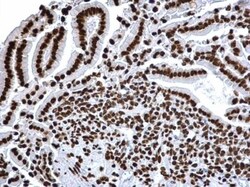
HIST1H3A, ac Lys18 Antibody, Novus Biologicals 0.1mL:Antibodies, Polyclonal

Learn More
HIST1H3A, ac Lys18 Antibody, Novus Biologicals™
Rabbit Polyclonal Antibody
Brand: Novus Biologicals NBP2-43535
Description
Specifically detects HIST1H3A (ac Lys18) in Human, Mouse, Rat samples, and it is validated for Chromatin Immunoprecipitation, Dot Blot, Immunocytochemistry, Immunofluorescence, Immunohistochemistry (Paraffin), Immunoprecipitation, Western Blotting
HIST1H3A Polyclonal specifically detects HIST1H3A in Human, Mouse, Rat samples. It is validated for Western Blot, Chromatin Immunoprecipitation, Immunohistochemistry, Immunocytochemistry/Immunofluorescence, Immunoprecipitation, Immunohistochemistry-Paraffin, Dot Blot.
Specifications
| HIST1H3A (ac Lys18) | |
| Polyclonal | |
| Western Blot 1:1000-1:10000, Immunohistochemistry, Immunocytochemistry/Immunofluorescence 1:100-1:1000, Immunoprecipitation 1:100-1:500, Immunohistochemistry-Paraffin 1:100-1:1000, Dot Blot, Chromatin Immunoprecipitation (ChIP) | |
| H3 histone family, member A, H3/A, H3FAHIST1H3E, H3FB, H3FC, H3FD, H3FF, H3FH, H3FI, H3FJ, H3FK, H3FL, HIST1H3B, HIST1H3C, HIST1H3D, HIST1H3F, HIST1H3G, HIST1H3H, HIST1H3I, HIST1H3J, histone 1, H3a, histone cluster 1, H3a, histone H3.1, Histone H3/a, Histone H3/b, Histone H3/c, Histone H3/d, Histone H3/f, Histone H3/h, Histone H3/i, Histone H3/j, Histone H3/k, Histone H3/l | |
| Rabbit | |
| Affinity Purified | |
| RUO | |
| Primary | |
| Human, Mouse, Rat | |
| IgG |
| Western Blot, Immunohistochemistry, Immunocytochemistry, Immunofluorescence, Immunoprecipitation | |
| Unconjugated | |
| PBS (pH 7), 20% Glycerol, 1% BSA with 0.025% Proclin 300 | |
| HIST1H3A | |
| Carrier-protein conjugated synthetic peptide encompassing a sequence within the N-terminus region of human Histone H3K18ac (acetyl Lys18). The exact sequence is proprietary. | |
| 0.1 mL | |
| Breast Cancer, Cancer, Cellular Markers, Core ESC Like Genes, Oncogenes, Protein Kinase, Stem Cell Markers, Tumor Suppressors | |
| 8350 | |
| Aliquot and store at -20C or -80C. Avoid freeze-thaw cycles. |
Your input is important to us. Please complete this form to provide feedback related to the content on this product.
For Research Use Only